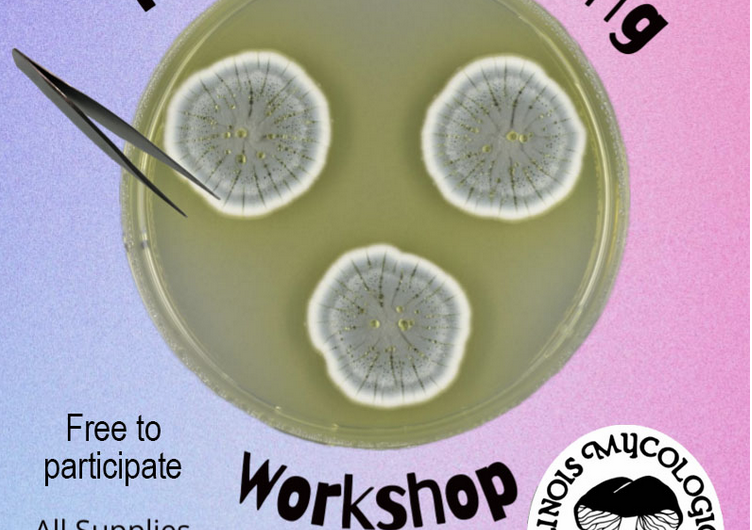

IMA CENTRAL Presents: Fungal Culturing Workshop
Saturday, January 24th
2:00 P.M.
Anita Purves Nature Center, Classroom AB
1505 N Broadway Ave, Urbana IL
Learn the basics of culturing mushrooms, observe their growth up close, and take home tips for safe and effective techniques. Open to all skill levels — whether you’re a curious beginner or a seasoned mycophile, come grow your knowledge (and your fungi)!
Free to Participate! All Supplies Provided!
